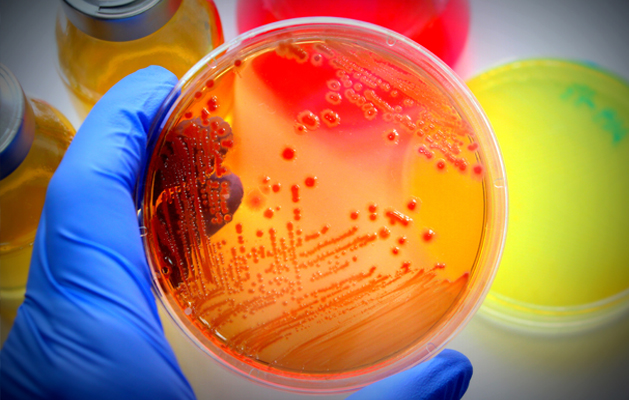
services-thumb
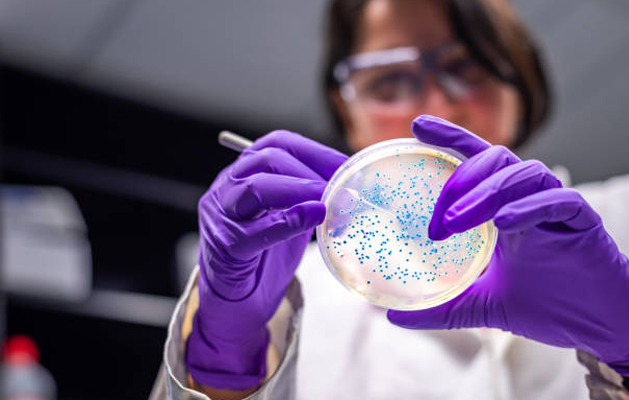
services-thumb

Our mission is to ensure the generation of accurate and precise findings.
Contact UsHead Office
The Microbiology Laboratory of Hare Diagnostics provides complete clinical services for the diagnosis, prevention and treatment of infectious diseases. Several techniques like microscopy, isolation on culture media, detection of antibodies, etc. are employed to identify the presence of potentially pathogenic microorganisms such as bacteria, fungi, viruses and parasites. Antimicrobial susceptibility tests are executed on isolates to identify the most appropriate antibiotic for treating an infection.
The laboratory is equipped with automated systems to address blood culture and mycobacterium culture, bacterial determination and antimicrobial susceptibility thus shortening the turnaround time for reporting.
Quality control and quality assurance are held in highest regard in the lab.